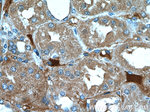
PANX2 Antibody in Immunohistochemistry (Paraffin) (IHC (P))
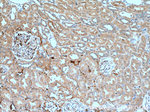
PANX2 Antibody in Immunohistochemistry (Paraffin) (IHC (P))

Search
Proteintech
PANX2 Polyclonal Antibody
{{$productOrderCtrl.translations['antibody.pdp.commerceCard.promotion.promotions']}}
{{$productOrderCtrl.translations['antibody.pdp.commerceCard.promotion.viewpromo']}}
{{$productOrderCtrl.translations['antibody.pdp.commerceCard.promotion.promocode']}}: {{promo.promoCode}} {{promo.promoTitle}} {{promo.promoDescription}}. {{$productOrderCtrl.translations['antibody.pdp.commerceCard.promotion.learnmore']}}
产品信息
26604-1-AP
种属反应
宿主/亚型
分类
类型
抗原
偶联物
形式
浓度
规格
纯化类型
保存液
内含物
保存条件
运输条件
产品详细信息
Product # 26604-1-AP specifically recognizes the 70 kDa Panx2.
Immunogen sequence: ESDLMYDNV VRQLLAALAQ SNHDATPTVR DSGVQTVDPS ANPAEPDGAA EPPVVKRPRK KMKWIPTSNP LPQPFKEPLA IMRVENSKAE KPKPARRKTA TD (70-170 aa encoded by BC101023)
靶标信息
Gap junctions are channel-forming structures that allow direct metabolic and electrical communication between adjacent cells of almost all types in mammalian tissues. In the human body, they are absent only in adult skeletal muscle cells and some circulating blood cells. A gap junction is formed two hemichannels, one in each of the neighboring cells, composed of six subunits. In mice and humans, at least 20 connexin and 3 pannexin genes encode gap junction proteins. Connexins are only found in chordates, while pannexins are present in both chordate and invertebrate genomes. Pannexins, previously known as innexins, are predicted to have four transmembrane regions, two extracellular loops, one intracellular loop, and intracellular N- and C-termini. Both human and mouse genomes contain three pannexin-encoded genes. Pannexin 2 (Px2, PANX2) appears to be a brain specific gene, and is abundantly expressed in the central nervous system, as is pannexin 1. In many neuronal cell populations, including hippocampus, olfactory bulb, cortex, and cerebellum, pannexin 1 and pannexin 2 are co-expressed; in other brain regions such as white matter, only pannexin 1-positive cells are found.
仅用于科研。不用于诊断过程。未经明确授权不得转售。
生物信息学
蛋白别名: dJ402G11.9; h PX2; Pannexin-2; unnamed protein product
基因别名: hPANX2; PANX2; PX2
UniProt ID: (Human) Q96RD6, (Mouse) Q6IMP4
Entrez Gene ID: (Human) 56666, (Mouse) 406218